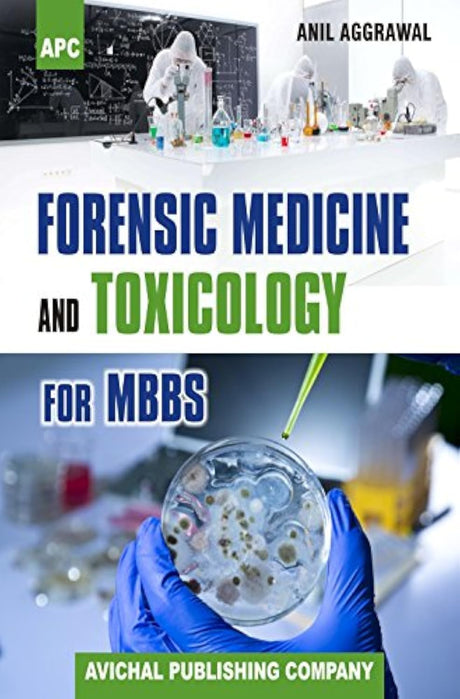

- 25% offNew arrival
Jaypee Brothers Medical Publishers
EPIDEMIOLOGY & PROGRAMMATIC MANAGEMENT OF NCDS IN INDIA
Sale price Rs.596.00 Regular price Rs.795.00Unit price /Unavailable - 20% offNew arrival
New Central Book Agency
Principles of Forensic Medicine: Including Toxicology
Sale price Rs.1,000.00 Regular price Rs.1,250.00Unit price /Unavailable Elsevier
MANSONS TROPICAL DISEASES WITH ACCESS CODE 24ED (IE)
Sale price Rs.6,817.00 Regular price Rs.9,418.00Unit price /UnavailableJaypee Brothers Medical Publishers
IAPSM's Textbook of Community Medicine
Sale price Rs.1,388.00 Regular price Rs.1,850.00Unit price /UnavailableElsevier
Textbook of Forensic Medicine and Toxicology: Principles and Practice, 6e
Sale price Rs.888.00 Regular price Rs.1,110.00Unit price /Unavailable- 28% offNew arrival
Jaypee Brothers Medical Publishers
GOLDEN NOTES FOR PREVENTIVE AND SOCIAL MEDICINE
Sale price Rs.866.00 Regular price Rs.1,195.00Unit price /Unavailable Elsevierindia
Gordis Epidemiology 7Ed (Pb 2025)
Sale price Rs.2,447.00 Regular price Rs.3,495.00Unit price /UnavailableAvichal Publishing Company
Essentials Of Forensic Medicine And Toxicology
Sale price Rs.756.00 Regular price Rs.995.00Unit price /Unavailable- 25% offNew arrival
Century Publications
NATIONAL HEALTH PROGRAMS OF INDIA 15 ED
Sale price Rs.975.00 Regular price Rs.1,300.00Unit price /Unavailable Elsevier
Community Medicine:Prep Manual for Undergraduates-4E
Sale price Rs.760.00 Regular price Rs.1,085.00Unit price /UnavailableOxford University Press, USA
Sale price Rs.4,500.00 Regular price Rs.5,295.00Unit price /UnavailableEvangel Publishing
FOGSI FOCUS on Micronutrients & Food Fortification
Sale price Rs.600.00 Regular price Rs.800.00Unit price /UnavailableParas Medical Books Pvt Ltd
Outline of Forensic Medicine and Toxicology 2nd/2016
Sale price Rs.425.00 Regular price Rs.575.00Unit price /UnavailableCentury Publications
Competency Based Practical and Viva Community Medicine 6th/2024
Sale price Rs.600.00 Regular price Rs.800.00Unit price /UnavailableVora Medical Publications
Epidemiology and Management for Health Care 7th/2024
Sale price Rs.675.00 Regular price Rs.750.00Unit price /UnavailableAvichal Publishing Company
Forensic Medicine And Toxicology For Mbbs
Sale price Rs.796.00 Regular price Rs.995.00Unit price /Unavailable